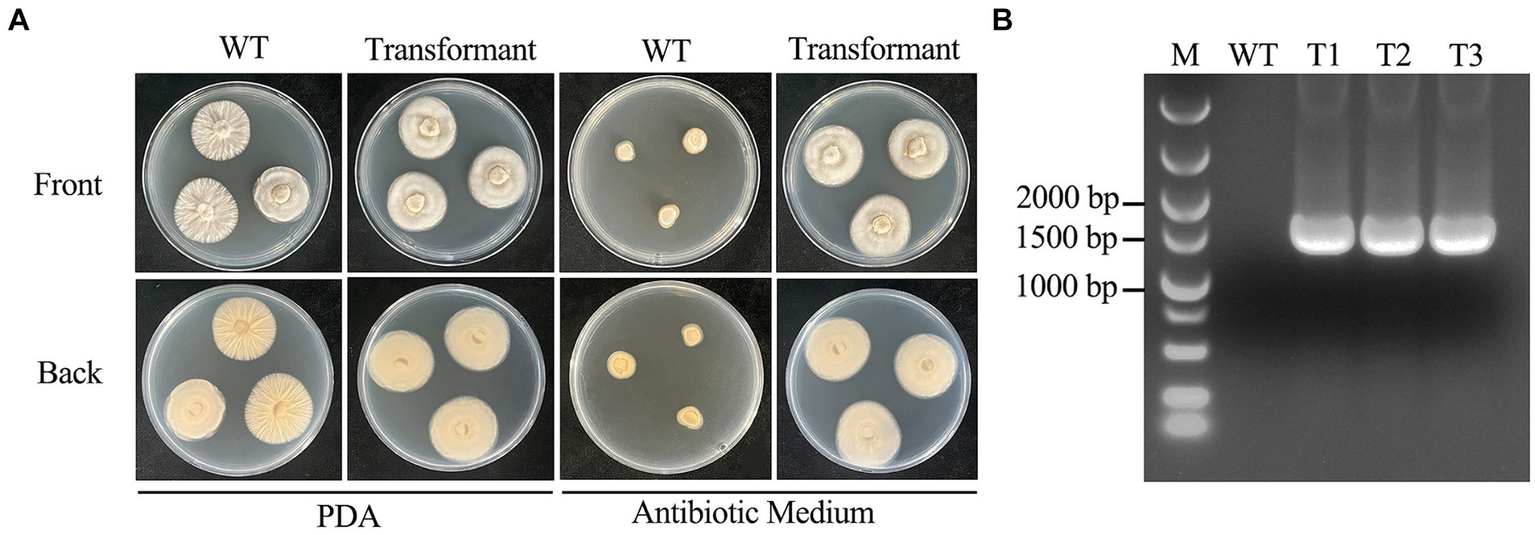

Abstract
Cordyceps chanhua is a well-known edible and medicinal mushroom with a long history of use in China, and it contains a variety of secondary metabolites with interesting bioactive ingredients. However, recent researches have mainly focused on cultivation conditions, secondary metabolite compositions and pharmacological activities of C. chanhua, the lack of an efficient and stable genetic transformation system has largely limited further research on the relationship between secondary metabolites and biosynthetic gene clusters in C. chanhua. In this study, single-factor experiments were used to compare the effects of different osmotic stabilizers, enzyme concentrations and enzyme digestion times on protoplast yield, and we found that the highest yield of 5.53 × 108 protoplasts/mL was obtained with 0.7 M mannitol, 6 mg/mL snail enzyme and 4 h of enzyme digestion time, and the regeneration rate of protoplasts was up to approximately 30% using 0.7 M mannitol as an osmotic stabilizer. On this basis, a PEG-mediated genetic transformation system of C. chanhua was successfully established for the first time, which lays the foundation for further genetic transformation of C. chanhua.
1 Introduction
Cordyceps chanhua, also known as Cordyceps cicada, is an entomopathogenic fungus of the genus Cordyceps in the family Claviciptaceae that can infest the nymphs of insects (e.g., Cicada flammata, Crytotympana pustulata) and form fruiting bodies on their body surfaces (Li et al., 2020, 2021). The fruiting bodies of C. chanhua have been used as traditional Chinese medicine for more than 1,600 years (Li et al., 2019). The wild-type strain is mainly distributed in eastern and southwestern China. Moreover, as an edible and medicinal resource, C. chanhua has high research and development value due to its various bioactive components, such as adenosine, amino acids, fatty acids, polysaccharides and ergosterol (Zhao et al., 2014; Sun et al., 2018; Zhang et al., 2019; Nxumalo et al., 2020; Raethong et al., 2023). Modern pharmacological studies have also confirmed its pharmacological efficacy as renoprotective, anti-inflammatory, antitumor, antidiabetic and immunomodulatory effects (Taofiq et al., 2016; He et al., 2018; Xu et al., 2018; Zhang et al., 2018; Zheng et al., 2018; Wang et al., 2019). Biomolecular research is crucial for the exploitation of these bioactive metabolites. However, at genetic level, the functional pharmacological studies of C. chanhua has been hindered by the lack of an efficient genetic tools such as transformation systems.
The development of genetic transformation techniques is a precondition that allows the targeting and efficiently modifying genes and may reveal the function of target genes (Li et al., 2017). Currently, there exist several common techniques for genetically transforming filamentous fungi, such as protoplast-mediated transformation (PMT), Agrobacterium-mediated transformation (AMT), shock-wave-mediated transformation (SWMT), electroporation (EP), biolistic transformation/particle bombardment (BT) and some genome editing tools [e.g., zinc-finger nucleases (ZFNs), transcription activator-like effector nucleases (TALENs), and the clustered regularly interspaced short palindromic repeat/associated protein 9 (CRISPR/Cas9)] (Díza et al., 2019; Ullah et al., 2020; Liang et al., 2021; Zhang et al., 2022). Overall, these manipulation techniques above mainly include random DNA integration, gene-targeting technology, RNA technology, and modern gene-editing technologies (Ullah et al., 2020). Despite these, fungal cell wall components are highly variable among different strains, no universal genetic transformation method can be applied for all filamentous fungal strains. Hence, it is of utmost importance to establish species-specific genetic manipulation methods for further research at the molecular level.
Specifically, the PMT fungal genetic manipulation method has the advantages of high transformation efficiency, gentle reaction conditions, and low cost (Díza et al., 2019). This approach involves the use of commercially accessible hydrolyzing enzymes to eliminate fungal cell walls, resulting in the production of protoplasts. Following this, certain chemical agents, such as polyethylene glycol (PEG) or calcium ions, facilitate the fusion and uptake of exogenous nucleic acids and protoplasts (Su et al., 2021). In similar applications, the selection of an appropriate cell wall degrading enzyme and its concentration is vital (Agrawal et al., 2015, 2022). Since the first successful transformation of yeast protoplasts using the PMT method by Hinnen et al. (1978), the method has become increasingly widely used and has been established in a number of filamentous fungi (e.g., Pleurotus eryngii, Ganoderma lucidum, Cordyceps militaris and Candida glycerinogenes) (Hinnen et al., 1978; Zhang et al., 2016; Lou et al., 2019; You et al., 2021; Zhang et al., 2022). It is noteworthy that the transformation rate is highly dependent on the cell wall-degrading enzymes (Zhang et al., 2016, 2022). Even, the source of variability for the osmotic stabilizers should be well considered as they are pivotal in upholding osmotic pressure and averting protoplast deformation/collapse (Dobrowolska and Staczek, 2009; Díza et al., 2019; Su et al., 2021). Up to date, an optimized PMT approach for fungi particularly in the case of C. chanhua is still controversial. More efforts should be developed about the protoplast yield as affected by the enzyme digestion time and concentrations.
In this study, we explored the optimization of protoplast preparation of C. chanhua strain 022017-3 and successfully established a simple, efficient and stable PEG-mediated protoplast transformation as a novel tool for the genetic transformation system of C. chanhua. In addition, PEG-mediated homologous recombination was used to test the transformation system of strain 022017-3 protoplasts. This is the first research report on the successful establishment of a genetic transformation system for C. chanhua, which is of great significance for the subsequent analyses of functional genes and the regulatory mechanisms of effective medicinal components.
2 Materials and methods
2.1 Fungal strains and culture conditions
The wild-type C. chanhua, strain 022017-3 was reserved in the Zhejiang Institute of Subtropical Crops, Zhejiang Academy of Agricultural Sciences, Wenzhou, China, and used to create the genetic system in this study. The mycelium of strain 022017-3 was picked and maintained on potato dextrose agar (PDA) medium at 24°C for 6–7 days. One 2 × 2 cm mycelial block on PDA solid medium was cut with a sterilized knife, placed in a 1.5 mL sterile centrifuge tube, fully ground with a sterile grinding rod, inoculated into 50 mL of potato dextrose broth (PDB) medium containing a concentration of 100 μg/mL ampicillin, and cultured at 24°C with 150 rpm for 3–4 days to collect mycelium.
2.2 Resistance gene selection and fungal sensitivity test
The hygromycin B is widely used as an antibiotic screening agent in fungal genetic transformation (Gritz and Davies, 1983; Ning et al., 2022; Li et al., 2023). The antibiotic sensitivity of C. chanhua strain 022017-3 was determined in PDA medium with different concentrations of hygromycin B (200, 250, 300, 350, 400, 450 μg/mL). The control group did not receive antibiotics. Petri dishes were incubated for 5 days at 24°C.
2.3 Preparation of protoplasts
2.3.1 Mycelium collection
The liquid medium was centrifuged at 5,000 rpm for 10 min to obtain the mycelium and then washed thrice with 30 mL of 0.7 M osmotic stabilizer.
2.3.2 Fungal cell wall lysis
Snail enzyme was used as a solvent, and 0.7 mol/L osmotic stabilizer was added to prepare the final concentration of snail enzyme solution. Then, 10 mL of enzyme solution was added to 5 g of mycelium and incubated for a period of time at 37°C and 150 rpm.
2.3.3 Protoplast collection
The above enzymatic solution was filtered with four layers of sterilized lens paper, and the filtrate was collected into a sterile 50 mL centrifuge tube at 4°C and 5,000 rpm for 10 min. The precipitate was the desired protoplasts.
2.3.4 Protoplast washing
Precooled STC buffer at 4°C was added to the protoplasts, and the volume was fixed to 20 mL and centrifuged at 5,000 rpm for 10 min at 4°C. This procedure was repeated twice. Protoplasts were observed under 40× microscopy, and the final concentration was adjusted to 108 protoplasts/mL by STC solution.
2.4 Single factor experiments of protoplast preparation
On the basis of pre-experiments, to select an efficient method for protoplast preparation, different osmotic stabilizers (0.7 M NaCl, 0.7 M KCl, 0.7 M MgSO4, 0.7 M mannitol and 0.7 M sucrose), snailase concentrations (2, 4, 6, 8, 10 and 12 mg/mL) and enzyme digestion times (2.5, 3, 3.5, 4, 4.5 and 5 h) were selected as influencing factors by single factor experiments with protoplast yield as the evaluation index.
2.5 Single factor experiments of protoplast regeneration
The regeneration of protoplasts was affected by the type of osmotic stabilizers in regeneration medium. In this experiment, four commonly used osmotic stabilizers (0.7 M KCl, 0.7 M NaCl, 0.7 M mannitol and 0.7 M sucrose) were selected, and a one-way test was carried out with osmotic stabilizer type as the influencing factor and the regeneration rate of protoplasts as the evaluation index. The medium composition used in this study was listed in Table 1. The concentration of protoplasts was adjusted from 108 protoplasts/mL to 103 protoplasts/mL with STC solution, and then 200 μL was taken and poured into melted 200 mL of regeneration solid medium and shaken slowly to mix well. PDA medium without osmotic stabilizers was used as a control. All the above plates were incubated at 24°C in the dark for 6 days. The protoplast regeneration rate = (the number of colonies in experimental group − the number of colonies in control group)/the number of protoplasts * 100%.
Table 1
| Medium | Composition |
|---|---|
| Potato dextrose agar (PDA) | Potato 200 g/L, dextrose 20 g/L, agar 15 g/L |
| Potato dextrose broth (PDB) | Potato 200 g/L, dextrose 20 g/L |
| Regeneration solid medium | Potato 200 g/L, dextrose 20 g/L, osmotic stabilizer 0.7 M, agar 15 g/L |
| Regeneration liquid medium | Potato 200 g/L, dextrose 20 g/L, osmotic stabilizer 0.7 M |
| Antibiotic medium | Potato 200 g/L, dextrose 20 g/L, agar 15 g/L, 300 μg/mL hygromycin B |
Medium composition for Cordyceps chanhua genetic transformation.
2.6 Plasmid construction
To construct the deletion cassette, 1–1.5 kb fragments upstream (Up) and downstream (Down) of the target gene and the hygromycin phosphotransferase gene (hyg) need to be obtained. The plasmid pKOV21 was used to obtain the hyg gene in this study. Fragments 1–1.5 kb upstream and downstream were amplified from the genomic DNA of strain 022017-3 using the indicated primers (Table 2). The double-joint PCR method was carried out to construct the combined knockout cassette (Yu et al., 2004). The above three fragments were purified with an Agarose Gel Extraction Kit PCR Clean-up Kit (VWI Biotech) and ligated by double-joint PCR in the order of “Up-hyg-Down.” The “Up-hyg-Down” fragment was assembled into the pGEM-T easy vector by the pGEM-T easy Vector System, Promega.
Table 2
| Primers | Oligonucleotide sequence (5′–3′) | Uses | Length of amplified sequence |
|---|---|---|---|
| up-F | AGGTAGTCCTTATATAGGGATAGC | Up flanks’ amplification for deletion cassete | 1.5 kb |
| up-R | GCTCCTTCAATATCATCTTCTCTCGAGCAGAGGGAAGCGACAACT | ||
| down-F | AGAGTAGATGCCGACCGAACAAGAAAGATGGAGGAAGCAATGTCG | Down flanks’ amplification for deletion cassete | 1.5 kb |
| down-R | CGGAAGAACGCAGTGTATCG | ||
| hyg-F | CGAGAGAAGATGATATTGAAGGAGC | hyg gene amplification and diagnostic PCR for transformants | 1.4 kb |
| hyg-R | TCTTGTTCGGTCGGCATCTACTCTA |
PCR primers for deletion cassette construction and transformants validation.
2.7 PEG-mediated protoplast transformation and verification of transformants
The 12 μg deletion cassettes were added to 850 μL of 108 mL−1 protoplasts and placed on ice for 25 min. Then, 1 mL of PTC solution was slowly added to the mixture and incubated on ice for 25 min. Subsequently, the above mixture was added to 20 mL of regeneration liquid medium and incubated overnight at 24°C and 100 rpm to revive the protoplasts. The revived protoplasts were added to 150 mL of prewarmed regeneration solid medium and gently mixed, after which the mixture was poured into a petri dish to form a thin layer and cultivated in a dark environment at 24°C for 1 to 2 days. Antibiotic medium containing 300 μg/mL hygromycin B was poured over the above regeneration solid medium petri dishes for screening in the dark at 24°C, and transformants were observed for approximately 5–7 days.
The transformants were picked out three times in antibiotic medium, and the third generation was incubated in PDB for genomic DNA extraction and amplified by PCR using the indicated primers to verify the accuracy of the transformants (Table 2).
2.8 Statistical analysis
Each experiment was performed at least in triplicate. Data were presented as the mean ± standard deviation (SD). The data analysis was performed using Microsoft Excel and SPSS software (SPSS Inc., Ver.19, IL, United States). A one-way analysis of variance (ANOVA) was used to analyze the significance difference using Duncan’s multiple range test (p ≤ 0.05).
3 Results
3.1 Resistance gene selection and fungal sensitivity test
Suitable selection markers are important for the establishment of genetic transformation systems in filamentous fungi, which can be used to distinguish transformants from nontransformants (Ruiz-Díez, 2002). In this study, the sensitivity of C. chanhua to hygromycin B was tested, and it was found that the growth of strain 022017-3 was inhibited at a concentration of 300 μg/mL (Figure 1).
Figure 1

Sensitivity of wild type strain 022017-3 toward hygromycin B. PDA medium was supplemented with different concentrations of hygromycin B (200–450 μg/mL) and PDA without hygromycin B (CK) were incubated for 5 days at 24°C.
3.2 Effect of different osmotic stabilizers on protoplast yield
An optimal osmotic stabilizer can maintain cell conformation and prevent cell membrane rupture. As shown in Figure 2A, 0.7 M NaCl was the most effective osmotic stabilizer for protoplast preparation, with the highest protoplast yield of 4.36 × 108 protoplasts/mL, followed by 0.7 M KCl at 2.13 × 108 protoplasts/mL. In addition, with mannitol and sucrose as the osmotic stabilizer, the mycelium would be suspended in the upper layer of the liquid, and it was difficult to precipitate it by increasing the centrifugation speed and prolonging the centrifugation time, which would reduce the amount of mycelium and decrease the accuracy of the results.
Figure 2

Effect of osmotic stabilizers, enzymatic hydrolysis concentration and enzymatic hydrolysis time on protoplasts preparation of strain 022017-3. (A) Osmotic stabilizers. (B) Snailase concentration. (C) Enzymatic hydrolysis time (**p < 0.01 and *p < 0.05).
3.3 Effect of enzymatic hydrolysis concentration on protoplast yield
There was a significant difference in the number of protoplasts cleaved by different concentrations of snailase. Figure 2B shows that with the increase in enzymatic hydrolysis concentration from 2 to 6 mg/mL, the protoplasts had a rapid growth rate. At an enzymatic hydrolysis concentration of 6 mg/mL, the protoplast yield reached 5.53 × 108 protoplasts/mL. As the enzymatic hydrolysis concentration was further elevated, there was a notable deceleration in the growth rate of protoplasts.
3.4 Effect of enzymatic hydrolysis time on protoplast yield
The enzymatic hydrolysis time also had a great influence on the production of protoplasts. Figure 2C shows that the protoplast yield increased as the enzymatic hydrolysis time increased from 2.5 to 4 h and slowly decreased after 4 h. In the preparation of protoplasts, 4 h was the most suitable enzymatic hydrolysis time, and the highest protoplast yield reached 4.36 × 108 protoplasts/mL.
3.5 Regeneration of Cordyceps chanhua strain 022017-3 protoplasts
Four osmotic stabilizers (0.7 M KCl, 0.7 M NaCl, 0.7 M mannitol and 0.7 M sucrose) were used to determine the regeneration rate of C. chanhua protoplasts. It was found that 0.7 M mannitol had the best effect, and the regeneration rate reached nearly 30% (Figure 3).
Figure 3

Effect of osmotic stabilizers on protoplasts regeneration of strain 022017-3 (**p < 0.01 and *p < 0.05).
3.6 Verification of transformants during protoplast transformation
In this study, we validated the transformation system by transferring the hyg gene into the C. chanhua genome. The strain successfully transferred with the hyg gene could grow normally in antibiotic medium. Eleven single colonies grew in antibiotic medium, those colonies were picked out three times in antibiotic medium, and the third generation was verified by diagnostic PCR. Finally, three correct transformants were obtained (Figure 4).
Figure 4
Morphological comparison of wild type strain 022017-3 with transformants and confirmation of transformants. (A) Phenotypes of wild type strain 022017-3 and transformant on PDA and antibiotic medium at 24°C for 6 days. (B) Diagnostic PCR to identify the transformants (M, Marker; WT, Wild Type; T1, Transformant 1; T2, Transformant 2; T3, Transformant 3).
4 Discussion
C. chanhua is a significant traditional Chinese medicine with a diverse array of bioactive constituents, indicating potential for broader applications through the investigation of these metabolites. Nevertheless, the lack of a genetic transformation platform has notably constrained the exploration of functional genes and secondary metabolite synthesis mechanisms in C. chanhua. While genetic transformation systems have been successfully developed for C. militaris within the Cordyceps genus, the transformation protocols vary considerably across different species (Sun et al., 2017; Meng et al., 2022). Hence, it is imperative to thoroughly examine the transformation manipulations in C. chanhua.
The yield and regeneration quality of protoplasts are influenced by multiple factors, including osmotic stabilizers, enzymatic hydrolysis concentration and time (Díza et al., 2019). Among them, osmotic stabilizers mainly play a role in maintaining the osmotic pressure of the cytoplasmic membrane system. Cell wall-degrading enzymes may damage the membrane system, inactivate the released protoplasts and make regeneration difficult, so an optimal osmotic stabilizer is needed to protect the protoplasts so that the internal and external pressure of the protoplasts remains balanced. To illustrate, 0.6–1.2 M sorbitol solution is used in the protoplast preparation of Amphichorda guana (Liang et al., 2021), Neurospora crassa (Case et al., 1979) and Aspergillus oryzae (Hahm and Batt, 1988) to maintain osmotic stability in protoplasts. Additionally, there exists a clear correlation between the concentration of hydrolyzing enzymes and the resulting protoplast yield (Wu et al., 2018). Increasing the concentration of hydrolyzing enzymes within a specific range enhances the liberation of protoplasts. However, once a certain threshold is reached, further increases in concentration do not lead to a significant rise in the number of protoplasts released. Based on the principle of cost-effectiveness, it is necessary to specify the optimal enzymatic concentration when the maximum protoplast yield is reached. Currently, the commonly used cell wall-degrading enzymes include snailase, driselase and lywallzyme (Han et al., 2020; Ning et al., 2022; Xie et al., 2022). Snailase is a complex enzyme that consists of over 20 different types of enzymes, e.g., cellulase, pectinase, mannanase, glucoamylase, chitinase and lipase (Liang et al., 2012). In present study, snailase was selected to degrade the cell wall of C. chanhua due to its low cost and is one of the effective enzymes for the preparation of fungal protoplasts. Furthermore, enzymatic hydrolysis time also has a considerable effect on protoplast yield. The young mycelium will be cleaved alongside the release of protoplasts, followed by the relatively older mycelium. Consequently, inadequate enzymatic hydrolysis duration may result in incomplete degradation of cell walls, while excessive duration may lead to potential damage to protoplasts, both of which will result in a lower protoplast yield and affect the regeneration rate of protoplasts (Agrawal et al., 2015; Ning et al., 2022).
In addition, transformation experiments showed that hyg gene could be successfully transferred into the genome of C. chanhua 022017-3 which ensured the mitotic stability of the transformants. About 11 transformants could be obtained from 12 μg of the deletion cassettes, and 3 of them were positive as identified by diagnostic PCR. The desirable transformation efficiencies proved that the established genetic transformation system could satisfy the needs for further genetic manipulation and research.
In fungi, the availability of transformation systems is crucial for investigating the functional roles of genes associated with the synthesis of specific metabolites or enzymes. Resistance genes are significant contributors to the genetic transformation of fungi, and mutant strains carrying resistance genes can be screened from wild-type strains by resistance screening medium. The hygromycin phosphotransferase gene is widely used as an antibiotic transformation marker in fungi, including Eutypella sp. (Ning et al., 2022), Poria cocos (Xie et al., 2022) and Gloeophyllum trabeum (Li et al., 2023). Here, we determined that the lowest hygromycin B inhibition concentration in C. chanhua 022017–3 was 300 μg/mL.
5 Conclusion
This study represented the first successful example of PMT system of the cordycipitoid fungus C. chanhua strain 022017-3 with excellence in transformation efficiencies. Preparation and regeneration of protoplasts are the basis for genetic transformation. We observed that the highest yield of 5.53 × 108 protoplasts/mL was obtained with 0.7 M mannitol, 6 mg/mL snail enzyme and 4 h of enzyme digestion time, and the regeneration rate of protoplasts was up to approximately 30% using 0.7 M mannitol as an osmotic stabilizer. However, the PMT system also has some limitations, such as low transformation efficiency and regeneration rate in C. chanhua, which require further studies to improve. In conclusion, the genetic transformation of C. chanhua described in this work will provide access to further investigate the functional genes and secondary metabolite synthesis mechanisms in C. chanhua.
Statements
Data availability statement
The original contributions presented in the study are publicly available. The Whole Genome Shotgun project has been deposited at DDBJ/ENA/GenBank under the accession JBELXZ000000000.
Author contributions
RC: Data curation, Formal analysis, Funding acquisition, Investigation, Methodology, Software, Writing – original draft, Writing – review & editing. YX: Formal analysis, Methodology, Writing – review & editing. JX: Data curation, Formal analysis, Writing – review & editing. KY: Data curation, Writing – review & editing. XL: Validation, Writing – review & editing. YC: Funding acquisition, Project administration, Writing – review & editing.
Funding
This research was supported by Wenzhou Basic Agricultural Science and Technology Project (Grant No. N20210008), Wenzhou Agricultural New Variety Breeding Cooperative Group Project (Grant No. 2019ZX003), Zhejiang Provincial Key R&D Plan Project (Grant No. 2020C02026) and Zhejiang Provincial Natural Science Foundation of China (Grant No. LQ24C150006).
Conflict of interest
The authors declare that the research was conducted in the absence of any commercial or financial relationships that could be construed as a potential conflict of interest.
Publisher’s note
All claims expressed in this article are solely those of the authors and do not necessarily represent those of their affiliated organizations, or those of the publisher, the editors and the reviewers. Any product that may be evaluated in this article, or claim that may be made by its manufacturer, is not guaranteed or endorsed by the publisher.
Supplementary material
The Supplementary material for this article can be found online at: https://www.frontiersin.org/articles/10.3389/fmicb.2024.1333793/full#supplementary-material
SUPPLEMENTARY FIGURE S1Construction of deletion cassette by PCR. (A)Up and down fragments of target gene. (B)Hyg fragment (M, Marker).
SUPPLEMENTARY FIGURE S2Up, hyg and down fragments of deletion cassette were assembled by double-joint PCR (M, Marker).
References
1
Agrawal R. Bhadana B. Chauhan P. S. Adsul M. Kumar R. Gupta R. P. et al . (2022). Understanding the effects of low enzyme dosage and high solid loading on the enzyme inhibition and strategies to improve hydrolysis yields of pilot scale pretreated rice straw. Fuel327:125114. doi: 10.1016/j.fuel.2022.125114
2
Agrawal R. Satlewal A. Gaur R. Mathur A. Kumar R. Gupta R. P. et al . (2015). Pilot scale pretreatment of wheat straw and comparative evaluation of commercial enzyme preparations for biomass saccharification and fermentation. Biochem. Eng. J.102, 54–61. doi: 10.1016/j.bej.2015.02.018
3
Case M. E. Schweizer M. Sidney R. K. Giles N. H. (1979). Efficient transformation of Neurospora crassa by utilizing hybrid plasmid DNA. Proc. Natl. Acad. Sci. U.S.A.76, 5259–5263. doi: 10.1073/pnas.76.10.5259
4
Díza A. Villanueva P. Oliva V. Gil-Durán C. Fierro F. Chávez R. et al . (2019). Genetic transformation of the filamentous fungus Pseudogymnoascus verrucosus of Antarctic origin. Front. Microbiol.10:2675. doi: 10.3389/fmicb.2019.02675
5
Dobrowolska A. Staczek P. (2009). Development of transformation system for Trichophyton rubrum by electroporation of germinated conidia. Curr. Genet.55, 537–542. doi: 10.1007/s00294-009-0264-8
6
Gritz L. Davies J. (1983). Plasmid encoded hygromycin B resistance: the sequence of hygromycin B phosphotransferase gene and its expression in Escherichia Coli and Saccharomyces Cerevisiae. Gene25, 179–188. doi: 10.1016/0378-1119(83)90223-8
7
Hahm Y. T. Batt C. A. (1988). Genetic transformation of an argB mutant of Aspergillus oryzae. Appl. Environ. Microbiol.54, 1610–1611. doi: 10.1128/aem.54.6.1610-1611.1988
8
Han G. Y. Liu N. Li C. L. Tu J. Li Z. Sheng C. Q. (2020). Discovery of novel fungal lanosterol 14#-demethylase (CYP51)/histone deacetylase (HDAC) dual inhibitors to treat azole-resistant candidiasis. J. Med. Chem.63, 5341–5359. doi: 10.1021/acs.jmedchem.0c00102
9
He L. F. Shi W. J. Liu X. C. Zhao X. H. Zhang Z. C. (2018). Anticancer action and mechanism of ergosterol peroxide from Paecilomyces cicadae fermentation broth. Int. J. Mol. Sci.19:3935. doi: 10.3390/ijms19123935
10
Hinnen A. Hicks J. B. Fink G. R. (1978). Transformation of yeast. Proc. Natl. Acad. Sci. U.S.A.75, 1929–1933. doi: 10.1073/pnas.75.4.1929
11
Li W. R. Ayers C. Huang W. P. Schilling J. S. Gullen D. Zhang J. W. (2023). A laccase gene reporting system that enables genetic manipulations in a brown rot wood decomposer fungus Gloeophyllum trabeum. Microbiol. Spectr.11, e04246–e04222. doi: 10.1128/spectrum.04246-22
12
Li Z. Z. Hywel-Jones N. L. Luan F. G. Zhang S. L. Sun C. S. Chen Z. A. et al . (2020). Biodiversity of cordycipitoid fungi associated with Isaria cicadae I: literature study. Mycosystema39, 2191–2201,
13
Li I. C. Lin S. Tsai Y. T. Hsu J. H. Chen Y. L. Lin W. H. et al . (2019). Cordyceps cicadae mycelia and its active compound HEA exert beneficial effects on blood glucose in type 2 diabetic db/db mice. J. Sci. Food Agric.99, 606–612. doi: 10.1002/jsfa.9221
14
Li Z. Z. Luan F. G. Hywel-Jones N. L. Zhang S. L. Chen M. J. Huang B. et al . (2021). Biodiversity of cordycipitoid fungi associated with Isaria cicadae Miquel II: teleomorph discovery and nomenclature of chanhua, an important medicinal fungus in China. Mycosystema40, 95–107,
15
Li D. D. Tang Y. Lin J. Cai W. W. (2017). Methods for genetic transformation of filamentous fungi. Microb. Cell Factories16:168. doi: 10.1186/s12934-017-0785-7
16
Liang M. Li W. Qi L. D. Chen G. C. Cai L. Yin W. B. (2021). Establishment of a genetic transformation system in guanophilic fungus Amphichorda guana. J. Fungi7:138. doi: 10.3390/jof7020138
17
Liang K. H. Zhang Q. H. Cong W. (2012). Enzyme-assisted aqueous extraction of lipid from microalgae. J. Agric. Food Chem.60, 11771–11776. doi: 10.1021/jf302836v
18
Lou H. W. Ye Z. W. Yu Y. H. Lin J. F. Guo L. Q. Chen B. X. et al . (2019). The efficient genetic transformation of Cordyceps militaris by using mononuclear protoplasts. Sci. Hortic.243, 307–313. doi: 10.1016/j.scienta.2018.08.043
19
Meng G. L. Wang X. P. Liu M. Q. Wang F. Liu Q. Z. Dong C. H. (2022). Efficient CRISPR/Cas9 system based on autonomously replicating plasmid with an AMA1 sequence and precisely targeted gene deletion in the edible fungus, Cordyceps militaris. Microb. Biotechnol.15, 2594–2606. doi: 10.1111/1751-7915.14107
20
Ning Y. D. Hu B. Yu H. B. Liu X. Y. Jiao B. H. Lu X. L. (2022). Optimization of protoplast preparation and establishment of genetic transformation system of an arctic-derived fungus Eutypella sp. Front. Microbiol.13:769008. doi: 10.3389/fmicb.2022.769008
21
Nxumalo W. Elateeq A. A. Sun Y. F. (2020). Can Cordyceps cicadae be used as an alternative to Cordyceps militaris and Cordyceps sinensis?—A review. J. Ethnopharmacol.257:112879. doi: 10.1016/j.jep.2020.112879
22
Raethong N. Thananusak R. Cheawchanlertfa P. Prabhakaran P. Rattanaporn K. Laoteng K. et al . (2023). Functional genomics and systems biology of Cordyceps species for biotechnological applications. Curr. Opin. Biotechnol.81:102939. doi: 10.1016/j.copbio.2023.102939
23
Ruiz-Díez R. (2002). Strategies for the transformation of filamentous fungi. J. Appl. Microbiol.92, 189–195. doi: 10.1046/j.1365-2672.2002.01516.x
24
Su Z. Z. Dai M. D. Zhu J. N. Zeng Y. L. Lu X. J. Liu X. H. et al . (2021). An efficient genetic manipulation protocol for dark septate endophyte Falciphora oryzae. Biotechnol. Lett.43, 2045–2052. doi: 10.1007/s10529-021-03171-5
25
Sun Y. F. Sum Y. Wang Z. A. Han R. L. Lu H. F. Zhang J. L. et al . (2018). Isaria cicadae conidia possess antiproliferative and inducing apoptosis properties in gynaecological carcinoma cells. Mycoloy8, 327–334. doi: 10.1080/21501203.2017.1386243
26
Sun D. Zhang M. Xie C. R. Guo X. W. Xu H. H. Gao H. T. et al . (2017). Establishment of genetic transformation system of Cordyceps militaris using PEG mediated method. Chin. Biotechnol.34, 76–82,
27
Taofiq O. Martins A. Barreiro M. F. Ferreira I. C. F. R. (2016). Anti-inflammatory potential of mushroom extracts and isolated metabolites. Trends Food Sci. Technol.50, 193–210. doi: 10.1016/j.tifs.2016.02.005
28
Ullah M. Xia L. Xie S. Sun S. (2020). CRISPR/Cas9-based genome engineering: a new breakthrough in the genetic manipulation of filamentous fungi. Biotechnol. Appl. Biochem.67, 835–851. doi: 10.1002/bab.2077
29
Wang Y. B. He P. F. He L. Huang Q. R. Cheng J. W. Li W. Q. et al . (2019). Structural elucidation, antioxidant and immunomodulatory activities of a novel heteropolysaccharide from cultured Paecilomyces cicadae (Miguel.) Samson. Carbohydr. Polym.216, 270–281. doi: 10.1016/j.carbpol.2019.03.104
30
Wu C. H. Jiang P. Zhao J. Fu H. H. (2018). High efficiency of protoplast preparation for artificially cultured Ulva prolifera (Ulvophyceae, Chlorophyta). J. Oceanol. Limnol.36, 1806–1811. doi: 10.1007/s00343-018-7058-0
31
Xie Z. N. Zhong C. Liu X. L. Wang Z. L. Zhou R. R. Xie J. et al . (2022). Genome editing in the edible fungus Poria cocos using CRISPR-Cas9 system integrating genome-wide off-target prediction and detection. Front. Microbiol.13:966231. doi: 10.3389/fmicb.2022.966231
32
Xu Z. C. Yan X. T. Song Z. Y. Li W. Zhao W. B. Ma H. H. et al . (2018). Two heteropolysaccharides from Isaria cicadae Miquel differ in composition and potentially immunomodulatory activity. Int. J. Biol. Macromol.117, 610–616. doi: 10.1016/j.ijbiomac.2018.05.164
33
You H. Sun B. Li N. Xu J. W. (2021). Efficient expression of heterologous genes by the introduction of the endogenous glyceraldehyde-3-phosphate dehydrogenase gene intron 1 in Ganoderma lucidum. Microb. Cell Factories20:164. doi: 10.1186/s12934-021-01654-8
34
Yu J. H. Hamari Z. Han K. H. Seo J. A. Reyes-Dominguez Y. Scazzocchio C. (2004). Double-joint PCR: a PCR-based molecular tool for gene manipulations in filamentous fungi. Fungal Genet. Biol.41, 973–981. doi: 10.1016/j.fgb.2004.08.001
35
Zhang X. F. Hu Q. B. Weng Q. F. (2019). Secondary metabolites (SMs) of Isaria cicadae and Isaria tenuipes. RSC Adv.9, 172–184. doi: 10.1039/c8ra09039d
36
Zhang Q. P. Olatunji O. J. Chen H. X. Tola A. J. Oluwaniyi O. O. (2018). Evaluation of the anti-diabetic activity of polysaccharide from Cordyceps cicadae in experimental diabetic rats. Chem. Biodivers.15:e1800219. doi: 10.1002/cbdv.201800219
37
Zhang Q. Zhao L. T. Shen M. Y. Liu J. Y. Li Y. R. Xu S. et al . (2022). Establishment of an efficient polyethylene glycol (PEG)-mediated transformation system in Pleurotus eryngii var. ferulae using comprehensive optimization and multiple endogenous promoters. J. Fungi8:186. doi: 10.3390/jof8020186
38
Zhang C. Zong H. Zhuge B. Lu X. Y. Fang H. Y. Zhu J. L. et al . (2016). Protoplast preparation and polyethylene glycol (PEG)-mediated transformation of Candida glycerinogenes. Biotechnol. Bioprocess Eng.21, 95–102. doi: 10.1007/s12257-015-0686-8
39
Zhao J. Xie J. Wang L. Y. Li S. P. (2014). Advanced development in chemical analysis of Cordyceps. J. Pharm. Biomed. Anal.87, 271–289. doi: 10.1016/j.jpba.2013.04.025
40
Zheng R. Zhu R. Li X. L. Li X. Y. Shen L. L. Chen Y. et al . (2018). N6-(2-hydroxyethyl) adenosine from Cordyceps cicadae ameliorates renal interstitial fibrosis and prevents inflammation via TGF-β1/Smad and NF-κB B signaling pathway. Front. Physiol.9:1229. doi: 10.3389/fphys.2018.01229
Summary
Keywords
Cordyceps chanhua , medicinal fungus, protoplast preparation, protoplast regeneration, genetic transformation
Citation
Cai R, Xiao Y, Xing J, Yu K, Li X and Chai Y (2024) Establishment of a genetic transformation system for cordycipitoid fungus Cordyceps chanhua. Front. Microbiol. 15:1333793. doi: 10.3389/fmicb.2024.1333793
Received
06 November 2023
Accepted
01 May 2024
Published
27 June 2024
Volume
15 - 2024
Edited by
Ruchi Agrawal, The Energy and Resources Institute, India
Reviewed by
C. Subathra Devi, VIT University, India
Umesh Jagtap, Rajaram College Kolhapur, India
Updates
Copyright
© 2024 Cai, Xiao, Xing, Yu, Li and Chai.
This is an open-access article distributed under the terms of the Creative Commons Attribution License (CC BY). The use, distribution or reproduction in other forums is permitted, provided the original author(s) and the copyright owner(s) are credited and that the original publication in this journal is cited, in accordance with accepted academic practice. No use, distribution or reproduction is permitted which does not comply with these terms.
*Correspondence: Yiqiu Chai, chaiyiqiu@qq.com
Disclaimer
All claims expressed in this article are solely those of the authors and do not necessarily represent those of their affiliated organizations, or those of the publisher, the editors and the reviewers. Any product that may be evaluated in this article or claim that may be made by its manufacturer is not guaranteed or endorsed by the publisher.